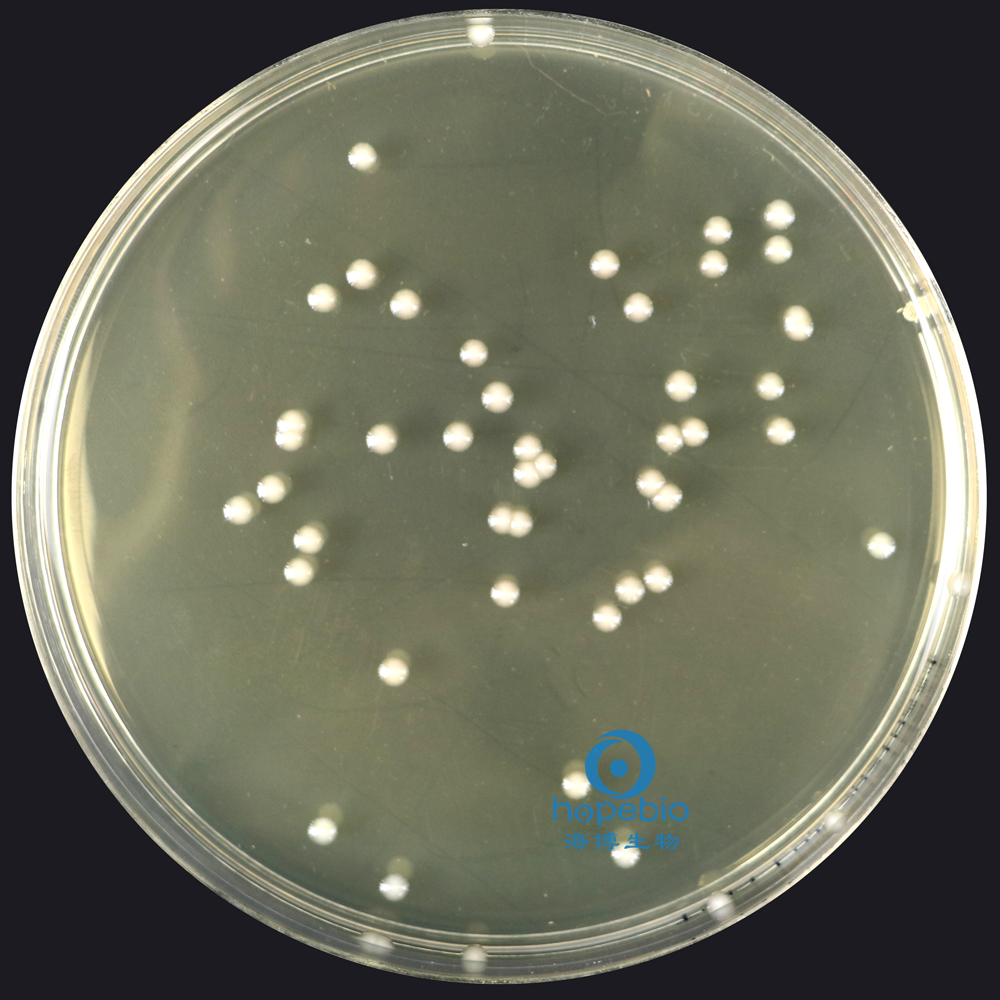
大肠埃希氏菌  无色透明大菌落
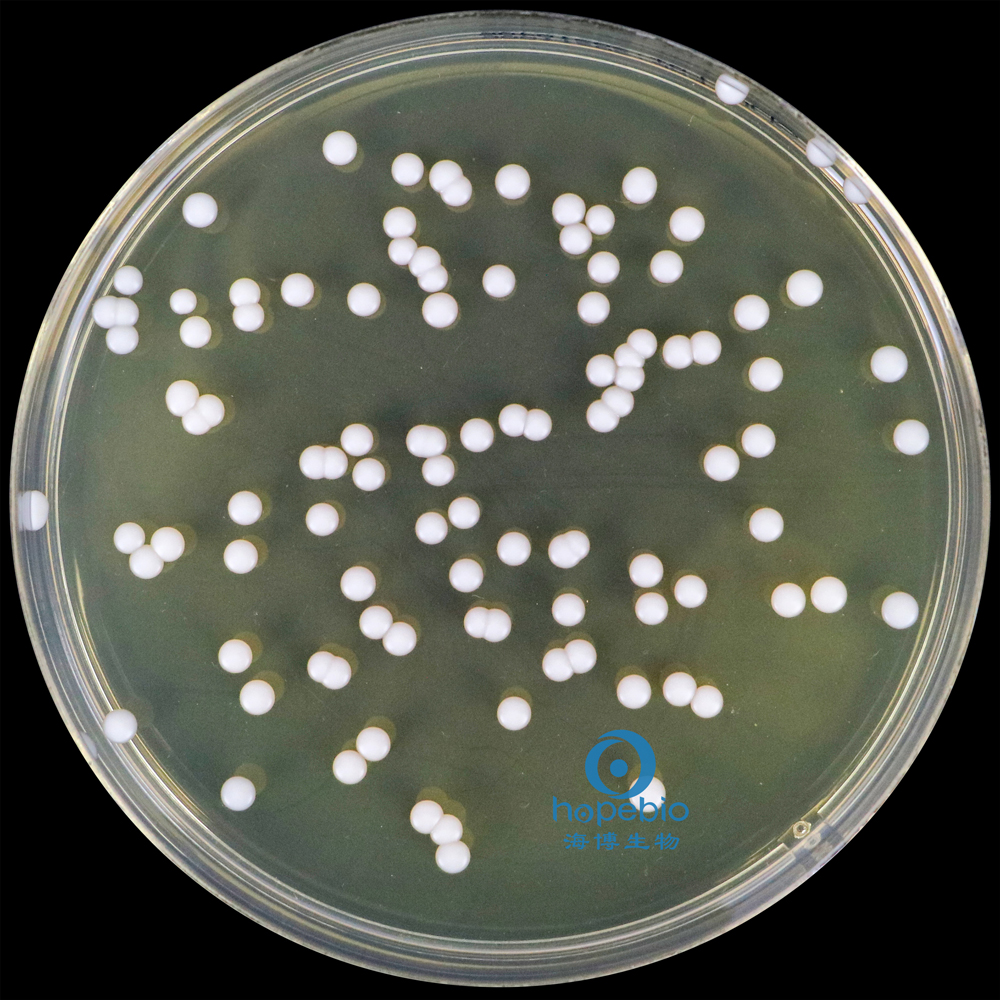
白色念珠菌  白色菌落
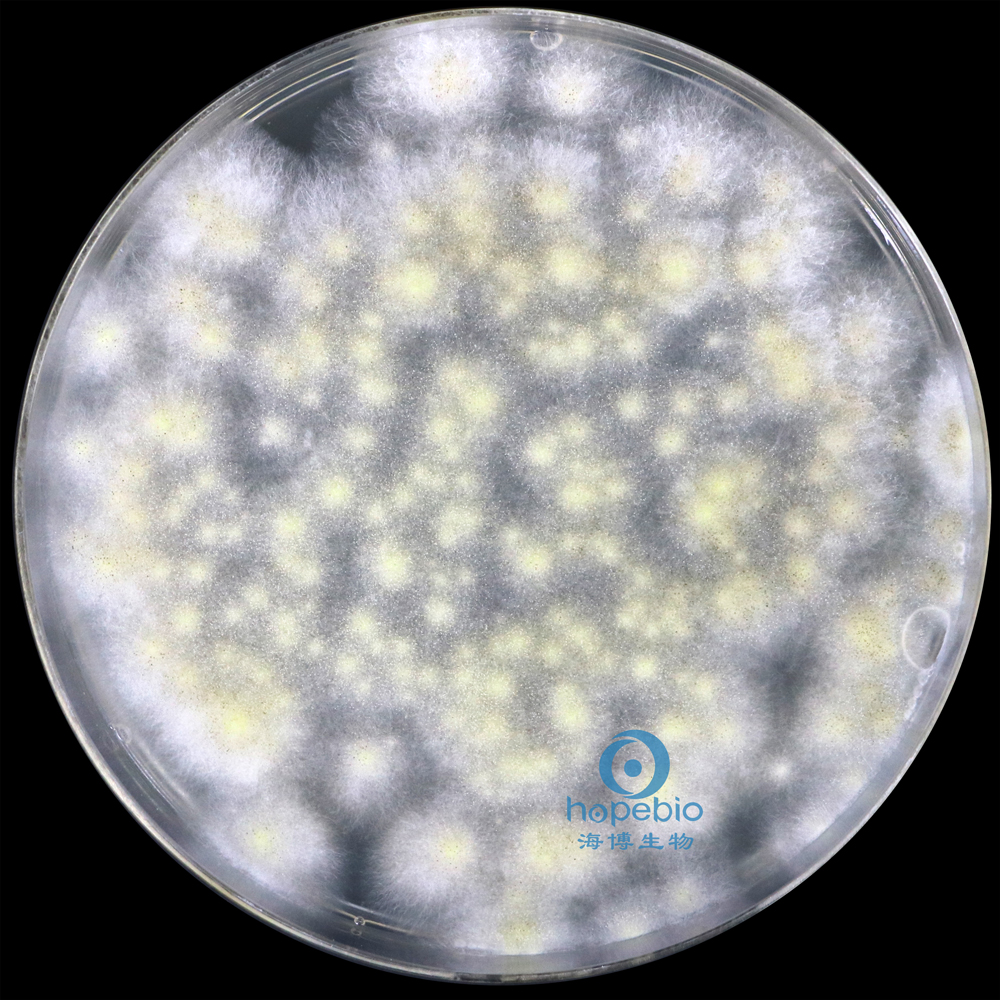
黑曲霉  白色菌丝

相关产品推荐更多 >
万千商家帮你免费找货
0 人在求购买到急需产品
- 详细信息
- 询价记录
- 文献和实验
- 技术资料
- 保存条件:
请置于阴凉避光处保存
- 保质期:
3年
- 英文名:
Tryptose Soya Agar
- 库存:
999
- 供应商:
青岛海博生物
- 规格:
250g
用途:一种通用的营养培养基,用于各种微生物的培养。
成分(g/L)
| 胰酪胨 | 15.0 |
| 大豆木瓜蛋白酶水解物 | 5.0 |
| 氯化钠 | 5.0 |
| 琼脂 | 15.0 |
| pH值7.3±0.2 | 25℃ |
检验原理:
胰酪胨、大豆木瓜蛋白酶水解物提供氮源、维生素和生长因子;氯化钠维持均衡的渗透压;琼脂是培养基的凝固剂。
用法:
称取本品40.0g,加热煮沸搅拌溶解于1000ml纯化水中,分装三角瓶,121℃高压灭菌15分钟,备用。
不同细菌在胰蛋白胨大豆琼脂培养基(TSA)上的生长特征:
![]() |
![]() |
|||
|
金黄se葡萄球菌 有黄色色素 |
大肠埃希氏菌 无色透明大菌落 |
|||
![]() |
![]() |
|||
|
鼠伤寒sha门氏菌 无色大菌落 |
铜绿假单胞菌 有绿色色素 |
|||
![]() |
![]() |
|||
|
枯草芽孢杆菌 白色不规则菌落 |
白色念珠菌 白色菌落 |
|||
![]() |
||||
|
黑qu霉 白色菌丝 |
||||
胰酪大豆胨琼脂培养基(TSA)(中国药典)微生物灵敏度试验:
按标签用法制备培养基,接种以下质控菌株,放置30-35℃需氧培养18-24小时。
注:回收率计算时,用TSA琼脂做对照培养基。


风险提示:丁香通仅作为第三方平台,为商家信息发布提供平台空间。用户咨询产品时请注意保护个人信息及财产安全,合理判断,谨慎选购商品,商家和用户对交易行为负责。对于医疗器械类产品,请先查证核实企业经营资质和医疗器械产品注册证情况。
- 作者
- 内容
- 询问日期
文献和实验15.0 5.0 30.0 15.0 25℃ 原理: 胰蛋白胨、大豆胨提供氮源、维生素和生长因子;氯化钠维持均衡的渗透压;琼脂是培养基的凝固剂。
250g(干粉) 沙氏葡萄糖琼脂培养基 Sabouraud Dextrose Agar 用于念珠菌的分离和鉴别。 (2010版中国药典) 021098 250g(干粉) 21098P1 90mm×20个 (平板培养基) 沙氏
)等都建立了各自的检测方法,所用培养基包括OXA、PAL、MMA、MOX、TSA—YE等,但只适用于李斯特菌的选择性分离培养,不能特异性分离单增李斯特菌。目前仍需一种选择性平板可以有效的分离单增李斯特菌。鉴于此,一些显色培养基如CHROMagar Listeria(法国科玛嘉)、HKListefia(广东环凯)等不断开发出来,用于单增李斯特菌的快速检测中,直接根据菌落颜色和形态就可对菌种作出鉴定,大大缩短了检测时间,提高了检测效率。本文通过对人工污染样品和实际样品检测,比较了CHROMagar
技术资料暂无技术资料 索取技术资料